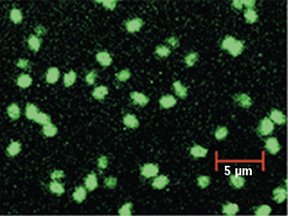

Chemists have fashioned tiny dots of carbon that glow in response to light. The nanoparticles may find uses in biological imaging as alternatives to quantum dots, fluorescent spheres of semiconductors.

Although scientists envision quantum dots in a variety of applications, the toxicity of their starting materials could limit their use, notes Ya-Ping Sun of Clemson (S.C.) University. The dots, from 2 to 10 nanometers (nm) across, are typically made of cadmium selenide or lead sulfide.
Sun and his colleagues set out to create glowing dots from a nontoxic, inexpensive starting material: carbon.
They began by using a laser to break a carbon disk into particles each about 5 nm in diameter. A nitric acid bath oxidized the dots’ surfaces, and the scientists then added the organic chemical called polyethylene glycol. Once those strandlike molecules had coated the carbon, the dots fluoresced when activated by colored lights, the researchers report in the June 21 Journal of the American Chemical Society.
Unlike the fluorescent colors of quantum dots, the colors emitted by the new carbon dots depend on the color of light that the researchers use to excite them.
A quantum dot’s small volume forces its electrons to make large changes in energy in response to absorbed photons. When excited by a light source, the electrons emit energy that corresponds to a color determined by the dot’s size.
Sun speculates that the electrons creating the effect in carbon dots are confined to the dots’ surfaces rather than to their cores, so their color would depend upon surface chemistry. By precisely controlling the dots’ size and manipulating surface properties, scientists might be able to determine the emitted colors as they can with quantum dots, he says.
Sun and his colleagues have already used the carbon dots to label cells for microscopic imaging, and they are continuing to study the mechanisms behind the dots’ glow.
“It’s a very intriguing result,” says Michael S. Strano of the University of Illinois at Urbana-Champaign. “Carbon is a very well studied material. To be able to produce a form of it that has new properties is always exciting.”
Although employing carbon dots would avoid the use of toxic metal ions, Strano notes, it’s not yet clear whether the carbon nanoparticles are graphite, which is stable, or an amorphous form of carbon, which might contain carcinogenic polyaromatic hydrocarbons.